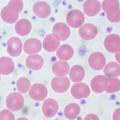
rak

Znana novinarka Pop TV, Damjana Seme, je javno spregovorila o svoji borbi z rakom, ki jo je skrivala kar dve leti. "Dve leti sem skrivala svojo zgodbo oziroma mojo diagnozo. Nisem želela, da kdo ve, kaj se mi dogaja, kaj preživljam," je za spletno stran 24ur.com začela svoj iskren zapis.
"Pa naj se vrnem dve leti nazaj. Grem na ultrazvok, tako kot vsako leto. Preventivno. Potem pa šok. Sumljiva tvorba. Takoj punkcija. Skoraj sem se onesvestila. Med punkcijo so mi tekle solze. Ne zaradi bolečin, ampak zaradi šoka. Zakaj jaz, kriči v meni. Vesolje, zakaj si izbralo prav mene za to borbo," je povedala o svojih začetnih strahovih, saj se je že od nekdaj najbolj bala ravno tega, da bi zbolela za rakom.
Po operaciji, pa se je soočila z novim strahom, kemoterapijo: "Ko sem okrevala po operaciji, me je začela grabiti panika zaradi kemoterapije, ki je sledila. Ker sem imela paničen strah pred njo, že od nekdaj, ne vem, zakaj, sem poiskala strokovno pomoč na zasebni kliniki za psihoonkologijo. Specialistka psihiatrije dr. Zvezdana Snoj, dr. med., se namreč ukvarja tudi z medicinsko hipnozo. Vsak teden sem hodila na terapije in hipnozo v Ljubljano. S pomočjo hipnoze sem premagala strah pred kemoterapijo."
Povedala pa je tudi, zakaj se je po dveh letih o svoji bolezni odločila javno spregovoriti. "In zakaj sploh pišem o vsem tem, se morda kdo sprašuje. Ni enostavno. Ker grem iz ene skrajnosti v drugo. Prej sem želela, da tega nihče ne ve, zdaj pa čutim, kot da je prav, da to povem. Ker je že vse mimo. In ker je to menda del terapije," je razkrila.
Dodala je še več zahval ožjim prijateljem, družini in zdravnikom ter povedala, da se je za službo razdajala dolgih 25 let, ker drugače ni znala, in da so ji delodajalci v težkih časih stali ob strani.

Če ne bi skrivala, bi bilo veliko lažje in mnogo manj stresno. Zakaj bi bolezen skrivali ? Je pa res , da si jo v večini primerov povzročimo sami, ampak se tega zavemo ,ko je že prepozno.